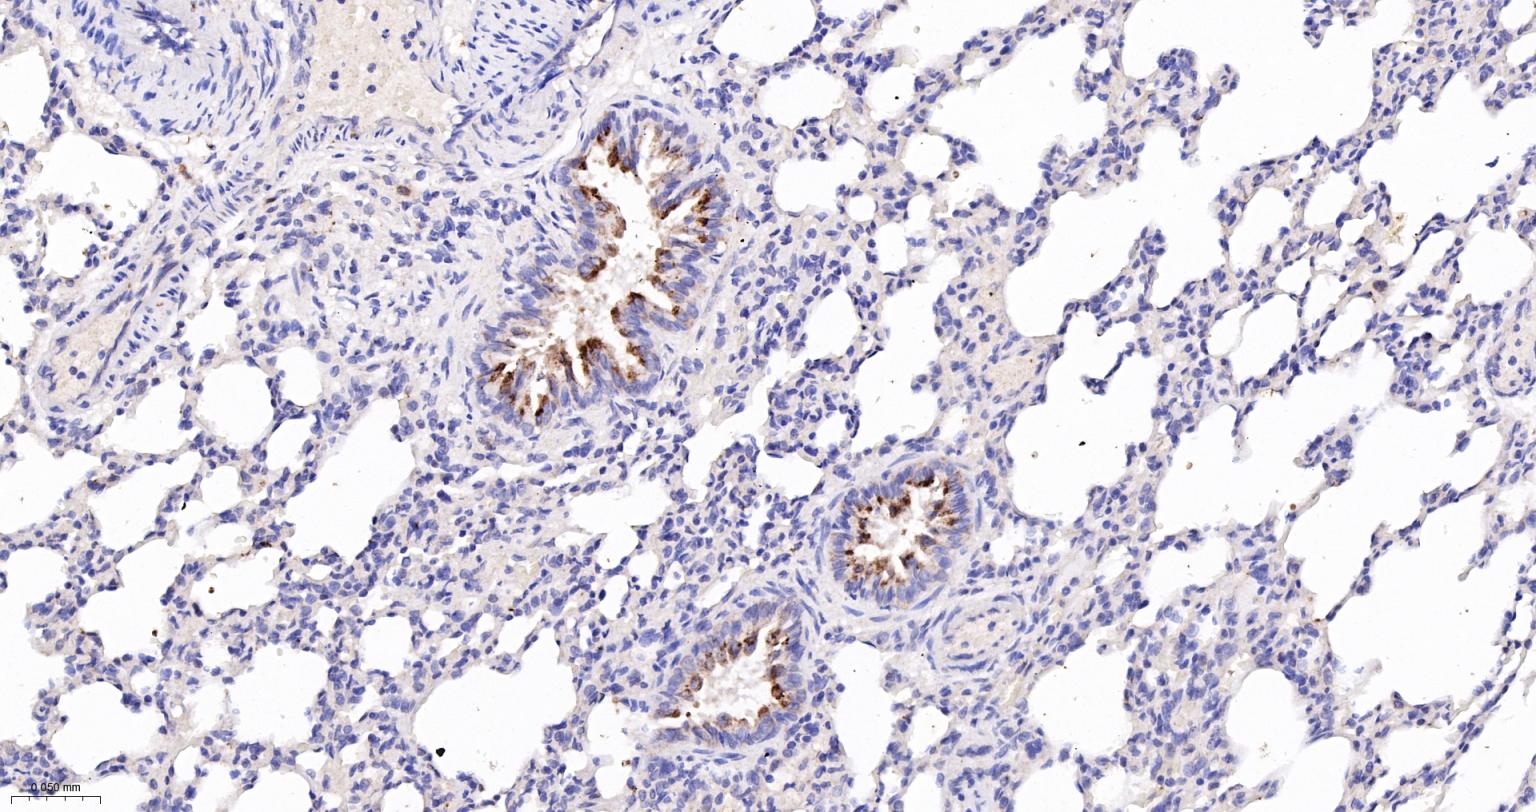
一氧化氮合成酶-2（诱导型）抗体-bs-0162R

NOS2/iNOS Rabbit pAb (一抗) - WB,IHC-P,IHC-F,IF,ELISA | Bioss

货号:bs-0162R
产品详情
相关标记
相关产品
相关文献
常见问题
概述
产品编号
bs-0162R
英文名称
NOS2/iNOS Rabbit pAb
中文名称
一氧化氮合成酶-2(诱导型)抗体
英文别名
HEP-NOS; INOS; NOS; NOS2A; MAC-NOS; NOS-II; Nos-2; i-NOS; NOS2_HUMAN; NOS2; Hepatocyte NOS (HEP-NOS); Inducible NO synthase (Inducible NOS | iNOS); NOS type II; Peptidyl-cysteine S-nitrosylase NOS2; 1.14.13.39; NOS2_MOUSE; Macrophage NOS (MAC-NOS); Inosl; NOS2_RAT;
抗体来源
Rabbit
免疫原
KLH conjugated synthetic peptide derived from human NOS-2: 101-200/1153
亚型
IgG
性状
Liquid
纯化方法
affinity purified by Protein A
克隆类型
Polyclonal
理论分子量
130 kDa
检测分子量
130 kDa
浓度
1mg/ml
储存液
0.01M TBS (pH7.4) with 1% BSA, 0.02% Proclin300 and 50% Glycerol.
研究领域
SWISS
Gene ID
保存条件
Shipped at 4℃. Store at -20℃ for one year. Avoid repeated freeze/thaw cycles.
注意事项
This product as supplied is intended for research use only, not for use in human, therapeutic or diagnostic applications.
数据库链接
产品介绍
合成与降解(Synthesis and Degradation)
催化生物体内一氧化氮(NO)生成的酶。分神经型一氧化氮合成的酶(nNOS or NOS-1)、诱导型一氧化氮合成的酶(iNOS or NOS-2)、内皮型一氧化氮合成的酶(eNOS or NOS-3)。
催化生物体内一氧化氮(NO)生成的酶。分神经型一氧化氮合成的酶(nNOS or NOS-1)、诱导型一氧化氮合成的酶(iNOS or NOS-2)、内皮型一氧化氮合成的酶(eNOS or NOS-3)。
背景资料
Nitric oxide (NO) is an inorganic, gaseous free radical that carries a variety of messages between cells. Vasorelaxation, neurotransmission and cytotoxicity can all be potentiated through cellular response to NO. NO production is mediated by members of the nitric oxide synthase (NOS) family. NOS catalyzes the oxidization of L-arginine to produce L-citrulline and NO. Two constitutive isoforms, brain or neuronal NOS (b or nNOS, type I) & endothelial cell NOS (eNOS, type III), and one inducible isoform (iNOS, type II), have been cloned. All NOS isoforms contain calmodulin, nicotinamide adenine dinucleotide phosphate (NADPH), flavin adenine dinucleotide (FAD), and flavin mononucleotide (FMN) binding domains. Nitric oxide synthase is expressed in liver, macrophages, hepatocytes, synoviocytes, stimulated glial cells and smooth muscle cells. Cytokines such as interferon-gamma (IFN), tumor necrosis factor (TNF), interleukin-1 and -2, and lipopolysaccarides (LPS) cause an increase in iNOS mRNA, protein, and activity levels. Protein kinase C-stimulating agents exhibit the same effect on iNOS activity. After cytokine induction, iNOS exhibits a delayed activity response which is then followed by a significant increase in NO production over a long period of time. Human iNOS is regulated by calcium/calmodulin (in contrast with mouse NOS2).

产品应用
| 应用 | 已检合格种属 | 预测种属 | 推荐稀释比例 |
|---|---|---|---|
| WB | Mouse, Rat | Human | 1:1000-5000 |
| IHC-P | Human, Mouse, Rat | 1:100-500 | |
| IHC-F | Human, Mouse, Rat | 1:100-500 | |
| IF | Human, Mouse, Rat | 1:100-500 | |
| ELISA | Human, Mouse, Rat | 1:5000-10000 |
交叉反应
交叉反应: Human, Mouse, Rat
相关产品
暂无相关产品
靶标
基因名
NOS2
蛋白名
Nitric oxide synthase, inducible
亚基
Homodimer. Binds SLC9A3R1.
亚细胞定位
Cytosol
组织特异性
Expressed in the liver, retina, bone cells and airway epithelial cells of the lung. Not expressed in the platelets.
相似性
Belongs to the NOS family.
Contains 1 FAD-binding FR-type domain.
Contains 1 flavodoxin-like domain.
Contains 1 FAD-binding FR-type domain.
Contains 1 flavodoxin-like domain.
功能
Produces nitric oxide (NO) which is a messenger molecule with diverse functions throughout the body. In macrophages, NO mediates tumoricidal and bactericidal actions. Also has nitrosylase activity and mediates cysteine S-nitrosylation of cytoplasmic target proteins such COX2.
同靶标产品
相关文献
提示: 发表研究结果有使用 bs-0162R 时请让我们知道,以便我们可以引用参考文章。作为回馈,资料提供者将获得我们送上的小礼品。
具体参考文献:bs-0162R 被引用于176文献中